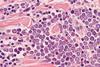
Microscopic,Image,(photomicrograph),Of,A,Merkel,Cell,Carcinoma,,A,Highly

All Brigham and Women's Hospital articles
-
 News
NewsNovel nasal spray effectively prevents influenza infection
The nasal spray reduced influenza virus levels by >99.99 percent, which could safeguard public health if validated in humans.
-
 News
NewsNew AI process for accurate enrolment of patients to clinical trial
The AI model screened the medical records of heart failure patients more accurately, quickly and cheaply, compared to study staff.
-
News
NewsHow PD-1 promotes Merkel cell carcinoma progression
Inhibiting mTOR signalling and neutralising mtROS suppressed MCC-PD-1-mediated tumour proliferation in mice.
-
 News
NewsPotential for improved rheumatoid arthritis treatment
Six types of inflammation with various cell types and disease pathways identified may provide better treatment of rheumatoid arthritis.
-
 News
NewsEngineered nanostructures enhance immune system’s ability to combat cancer
Important step achieved by US researchers as stable and potent immune therapy delivery system eradicates tumours in mouse models of melanoma, colon, and breast cancer, while preventing the formation of future tumour.



